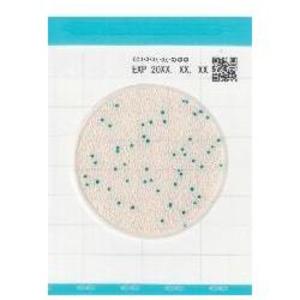
Фото Kikkoman Biochemifa Easy Plate CC Тест-пластины (100 шт)

Тест-пластины Kikkoman Biochemifa 61974 Easy Plate CC (100 шт)
Код товара: 0045248
Производитель: Kikkoman Biochemifa
Kikkoman Biochemifa Easy Plate CC - Тест-пластины
Тест-пластины Easy Plate СC представляет собой раскладывающуюся двойную пластиковую пленку, состоящую из верхнего прозрачного слоя с нанесенной сеткой и нижней подложки, покрытой в центральной части застывшим питательным гелем. Помимо микробиологической среды в состав этого геля включены хромогенные индикаторы для последующей идентификации анализируемых микроорганизмов по характерному окрашиванию их колоний.
Метод Easy Plate СC предназначен для выявления бактерий группы кишечной палочки в пищевых продуктах. Его можно рекомендовать в качестве альтернативы классическому методу проведения микробиологического анализа в чашках Петри, заполненных желчным фиолетово-красном агаром. Тест-пластины Easy Plate СC компактны, просты в использовании и характеризуются низким уровнем отходов, образующихся в процессе тестирования.
Метод посева на тест-пластины Easy Plate CC сертифицирован международной аналитической ассоциацией Association of Official Agricultural Chemists (AOAC Research Institute, Performance Tested Methods SM 021401) для микробиологического тестирования в пищевой промышленности.
Легко выявляемые яркоокрашенные колонии
Более надежная идентификация и быстрый подсчет колоний на пластинах Easy Plate СC по сравнению с классическими микробиологическими процедурами на агаризованных чашках Петри.Высокая корреляция с классическими методом
Данные микробиологического анализа разных пищевых продуктов на пластинах Easy Plate CC хорошо коррелируют с результатами подсчета колоний на агаризованных чашках Петри (Desoxycholate agar и VRB agar)
Корреляционный анализ результатов параллельных микробиологических тестов (Easy Plate CC / Desoxycholate agar и Easy Plate CC / VRB agar).
- Одобрен международной ассоциацией AOAC
Получен сертификат AOAC по программе PTM.
- Микроорганизмы — Колиформные бактерии
- Время инкубации — 48 ч
- Упаковка — 4 х 25 шт.
- Страна производства — Япония